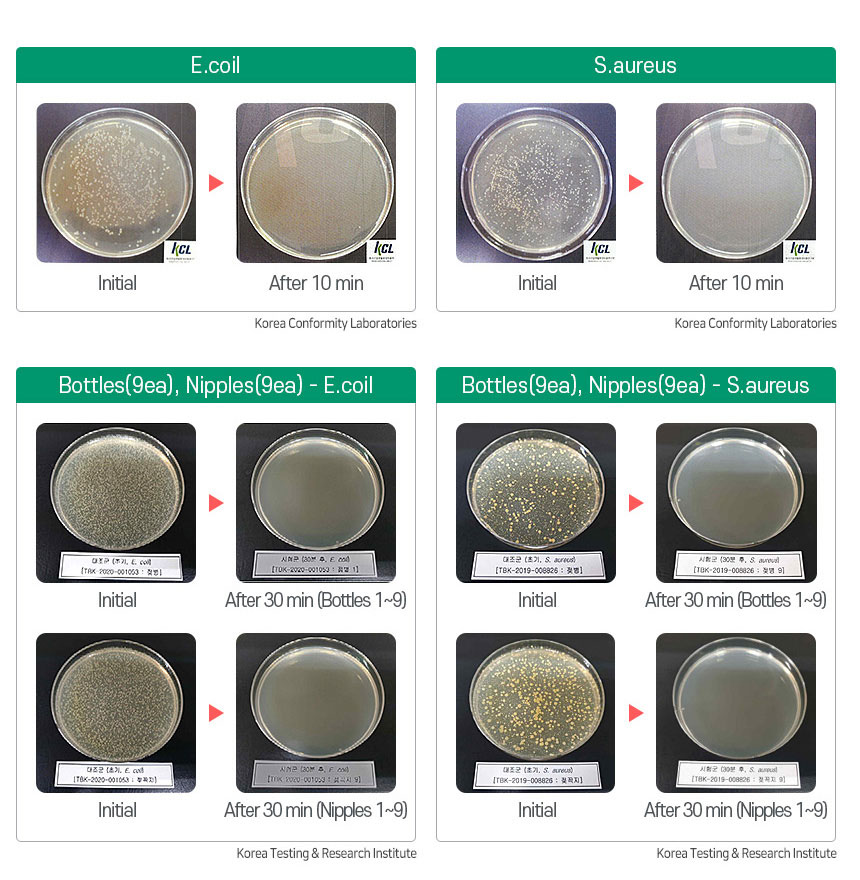

Babyken Singapore
Haenim Smart DUO UV-C Sterilizer (Cream White)
Haenim Smart DUO UV-C Sterilizer (Cream White)
APOSH BIZHUB
1 Yishun Industrial Street 1
#04-07 APosh Bizhub
Singapore 768160
Singapore
Choose options

π WHY CHOOSE THE HAENIM SMART DUO STERILIZER? π
π°π· Premium Quality, Made in Korea: Authentically manufactured in South Korea, guaranteeing top-tier durability, safety, and craftsmanship.
π‘οΈ Ultimate 99.999% Sterilization: Powered by 18 Premium OSRAM UV-C LEDs (12 top / 6 bottom) and a Super Mirror Stainless-Steel Interior that maximizes light reflection for flawless, blind-spot-free sterilization.
π¨ Aesthetic Pastel Colors: Designed to elevate your kitchen or nursery! Available in 3 gorgeous, modern finishes: Cream White, Cream Beige, and Cream Pink.
-
π‘οΈ Smart 3-Level Temperature Control: 100% safe for all baby items! Customize your drying with an advanced PTC Heater to prevent melting or warping:
COOL: Natural Air Drying (heat-free!)
LOW: Gentle heat below 45Β°C
HIGH: Deep drying below 60Β°C
πΌ 24-Hour Automatic Storage Mode: Always have a clean bottle ready! Automatically runs a sterilization and ventilation cycle every 3 hours for up to 24 hours. Plus, opening and closing the door triggers a quick 1-minute UV refresh!
π Smart Auto-Resume: Need to grab a bottle mid-cycle? Open the door with no worriesβthe sterilizer will automatically resume its operation the moment you close it.
π€« Baby-Friendly Mute Function: Protect your little oneβs peaceful sleep! Simply press and hold the Clean button for 5 seconds to activate or deactivate all button sounds.
π§Ό Smart Cleaning Reminder: Takes the guesswork out of maintenance! It automatically monitors usage hours and alerts you when it's time for a wipe-down (recommended once a month). Reset the timer with just a single press!
π§Έ Adjustable Shelf System: Grows with your baby! Includes 2x Stainless Steel Shelves that can be adjusted to fit tall bottles, breast pump parts, and weaning bowls.
β‘ Energy Efficient: Powerful performance without the high electric bill. Operates at a rated power consumption of just 95W.
π¦ What's in the Box: Comes complete with the Haenim Smart Duo Unit, 2x Stainless Steel Shelves, 1x Wireless Water Tray Shelf (for super easy cleaning!), and Power Cord.
β Unbeatable Warranty & Safety: Features a built-in UV LED Error Detection system (displays [UE] on screen if service is needed). Backed by a 1-Year General Warranty PLUS a massive 5-Year Limited Warranty for the UV-LED Module!
π Product Specifications:
External Dimensions: (W) 295 x (D) 375 x (H) 425 mm
Internal Capacity: (W) 260 x (D) 288 x (H) 330 mm
Weight: 8kg (Net)
Voltage: AC 220V | 60Hz

